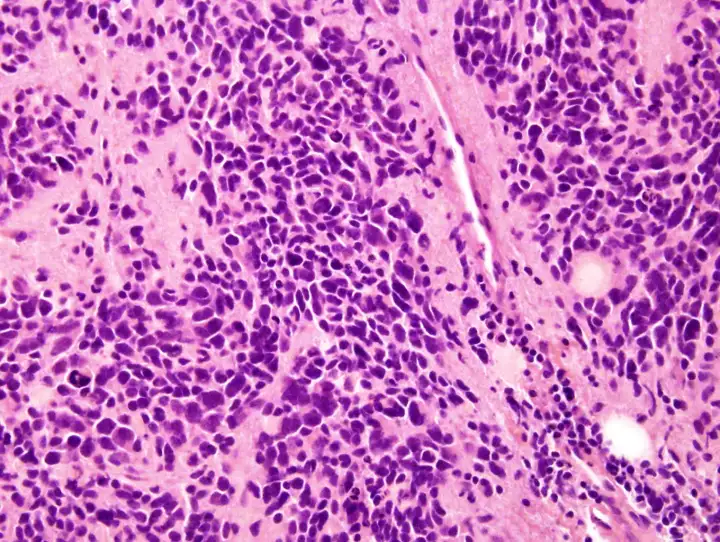

Терапия CAR-T клетками обычно неэффективна против солидных опухолей, таких как нейробластома, которая возникает, когда нервные клетки у детей превращаются в раковые. Подобные опухоли агрессивно сопротивляются атакам иммунной системы, поэтому добиться ремиссии у ребёнка с раком крови очень сложно.
Однако именно такая терапия, проведённая в 2005 году, позволила человеку со смертельной опухолью выйти в ремиссию на рекордные 18 лет. Это самая длительная ремиссия у пациента, который получил лечение CAR T-клетками. Фактически, ребёнок полностью излечился от нейробластомы, когда в 4 года врачи провели несколько курсов стандартного лечения, а затем прибегли к CAR-T клеткам как к последнему средству.
Для лечения обычно собирают образец иммунных Т-клеток из собственной крови пациента, а затем генетически модифицируют их для выявления и уничтожения раковых клеток. После модификации такие улучшенные клетки вводят обратно в организм. У Клиона Руни из США была особенно агрессивная опухоль, которая не поддавалась химио- и радиотерапии, но в итоге терапия Т-клетками его спасла.
Остальные девять участников программы в итоге умерли от рака, поэтому неясно, почему Руни отреагировал лучше других. Одной из причин может быть то, что Т-клетки каждого человека ведут себя по-разному в зависимости от генетики и состояния организма. Другое объяснение может заключаться в том, что опухоли некоторых участников были иммуносупрессивными, то есть сильнее сопротивлялись CAR T-клеткам. Поэтому сейчас команда, вылечившая Руни, изучает новые способы создания клеток, которые смогут лучше и эффективнее противостоять раку у разных людей.

